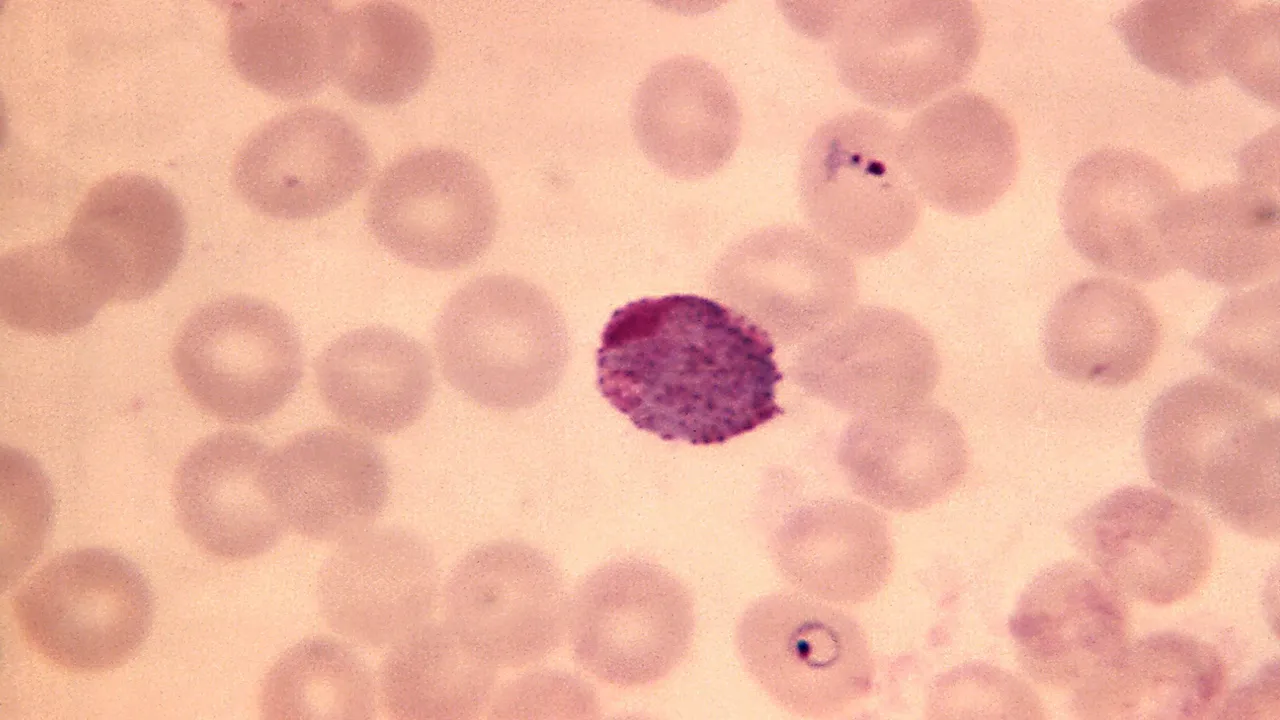
baarmoederhalsuitstrijkje

Slechts zes op de tien vrouwen laten uitstrijkje maken
20 jan 2020, 12:20 • Nieuws
CC0 via Pixnio
Het aantal vrouwen dat een uitstrijkje laat maken na een oproep tot deelname aan het bevolkingsonderzoek, stijgt niet meer.
Deden in het verleden zeven op de tien vrouwen mee aan dit onderzoek naar baarmoederhalskanker, nu zijn dat nog maar zes op de tien vrouwen.
Dat meldt de stichting Olijf, een patiëntenorganisatie voor vrouwen met gynaecologische kanker, in het kader van de Europese Baarmoederhalskanker Preventieweek. Jaarlijks krijgen 800 vrouwen in Nederland de diagnose baarmoederhalskanker, blijkt uit cijfers van het RIVM. Jaarlijks overlijden ongeveer 200 vrouwen aan de gevolgen daarvan.
Vooral vrouwen tussen de 35 en 50 jaar laten minder vaak een uitstrijkje maken. Volgens het RIVM kunnen veel meer gevallen worden opgespoord als meer vrouwen deelnemen.
Loading articles...
Loading






